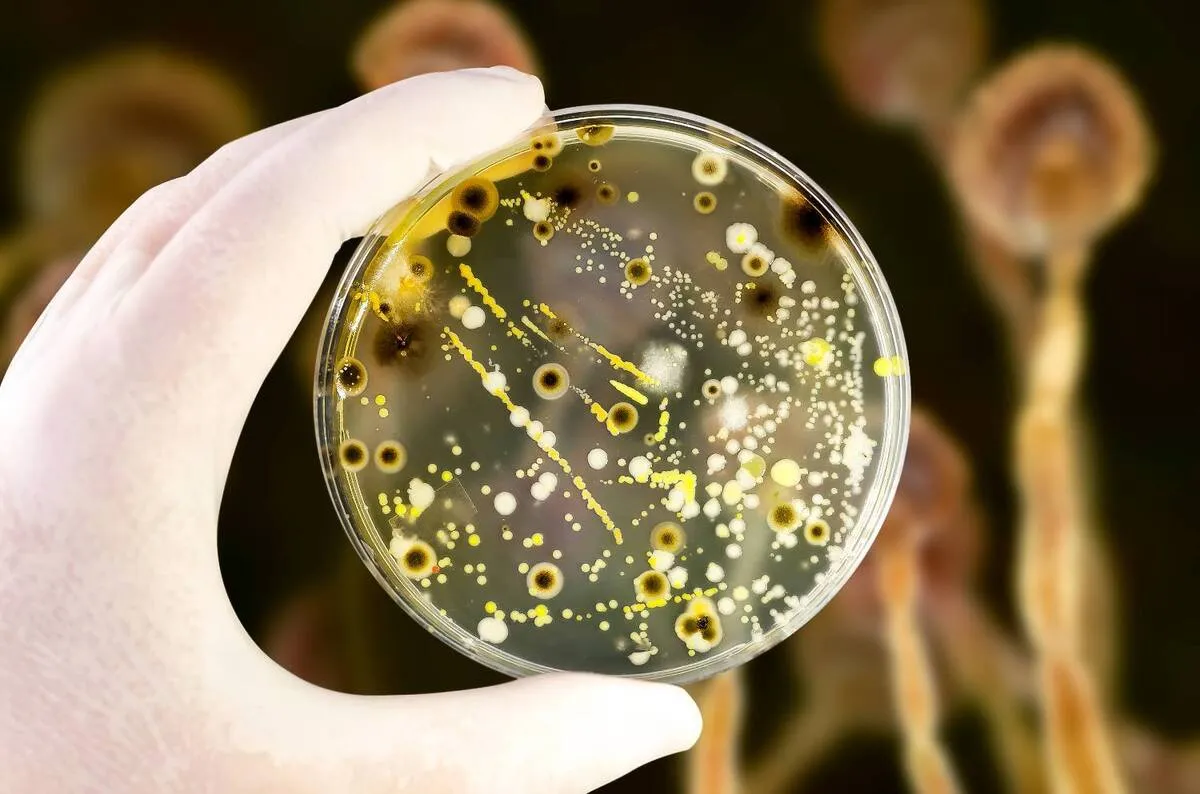

Scientists Study Microbial Resources for Industrial Applications
Liu Guangxiu, a researcher with the Northwest Institute of Eco-Environment and Resources of the Chinese Academy of Sciences, said that the institute's Key Laboratory of Extreme Environmental Microbial Resources and Engineering of Gansu Province houses these "treasures" collected from different extreme environments in China, including glaciers, permafrost, deserts and salt lakes, and even those carried into outer space via China's space program, the Xinhua reported.
Under the influence of global climate change and human activities, the resources of extremophilic microorganisms are declining, underscoring the importance of protecting and exploring these resources. The lab was established in 2019 for this purpose, according to Liu.
Extremophilic microorganisms have unique physiological functions and metabolic characteristics that enable them to adapt to harsh conditions, such as low temperatures, high temperatures, high salt concentrations, high pressure and strong radiation, making themselves the ideal subjects for studying the origin of life, said Liu.
The bioactive substances that they produce have special functions and wide-ranging applications in industries such as medicine, food, agriculture, the chemical industry and environmental protection.
The researchers are currently conducting classification studies on these valuable strains, said Liu.
In addition, Zhang Wei, director of the laboratory, said that they have carried out cooperation with 20 domestic and international research teams in the study, in areas such as the ecological cultivation of traditional Chinese medicine, the restoration of polluted water bodies and soil improvement.
4155/v





















